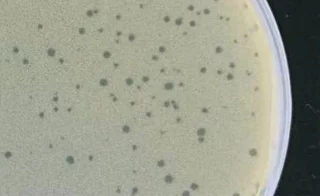
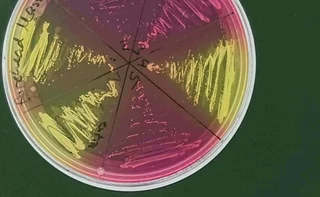

Bacteriophages are small molecular machines with huge potential for biotechnological and biomedical applications. Contrary to what is often portrayed, they are not killer machines that kill bacteria. Rather, like all viruses, the small bacterial viruses are in a state of equilibrium with their hosts. However, targeted interference with this equilibrium can lead to eradication of the host. This is used in phage therapy.
Although the history of biochemistry and molecular biology would be inconceivable without research on bacteriophages, little is known about the importance of phages for the balance of organisms in the biosphere.

The ubiquitous occurrence of phages wherever their hosts are found has always attracted hunters looking for new variants with novel properties. Did you know that one of the most important therapeutic phages was obtained from vegetable waste? The bacteriophage "Muddy", isolated from a rotten eggplant, has been used several times for the successful phage therapy of complicated infections with non-tuberculous mycobacteria (NTM).
In our PCR laboratory, scientists are also on the hunt for phages with therapeutic potential.
The characterization of the host bacteria is just as interesting as the characterization of the associated phages. The individuality of bacteria of the same species has long been underestimated. In phage research, however, this is demonstrated by the high specificity of the phages to their hosts and the development of resistance. The in-depth investigation of host bacteria in their interaction with their viruses using the tools of modern molecular biology is therefore just as exciting as the investigation of the viruses themselves.
Together with the Microbiome Center Regensburg (MCR) we are dedicated to understand the role of phages for the composition and function of the human microbiome und to develop novel phage-based strategies for a medical microbiome modulation.

We are very pleased to announce the 3rd Phage Symposium at the PCR in Regensburg. The meeting will take place at June 25, 2026. International experts will give presentations.
See here...
